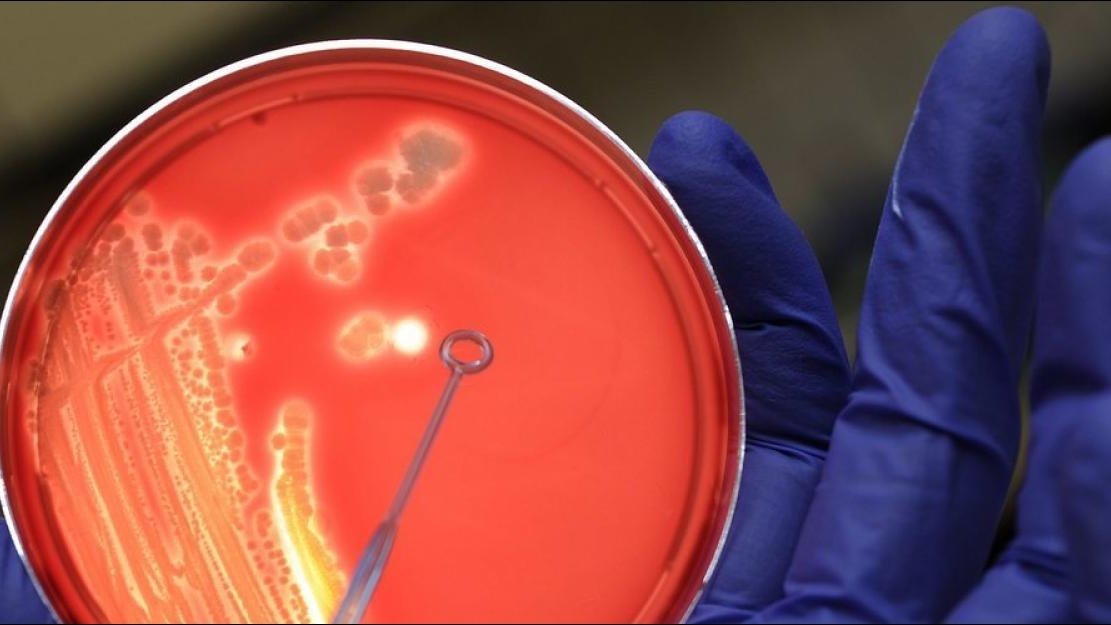

St.Galler Forscher entziehen Spitalkeimen die Grundlage
Manch einer, der ins Spital muss, wird dort erst recht krank. Durchschnittlich sieben Prozent aller Patienten in Industrieländern sind von derartigen «nosokomialen» Infektionen betroffen. Auf Intensivstationen steigt das Risiko nochmals deutlich an. Schwere Erkrankungen bis hin zu einer lebensbedrohlichen Blutvergiftung können die Folge sein.
Besonders leichtes Spiel haben die Krankenhauskeime, sobald ein Patient mit invasiven medizinischen Massnahmen behandelt wird: Steckt man Schläuche in den Körper, etwa um ihn zu beatmen, ihm Flüssigkeit zuzuführen oder Urin abzuleiten, fassen die Infektionserreger schnell Fuss. Wie solche Infektionen verhindert werden könnten, ist noch ungeklärt. Ein Team aus Empa-Forschern und Medizinern vom Kantonsspital St.Gallen arbeitet zurzeit an einem Projekt, das das Risiko von Spitalinfektionen senken soll.
Der Fokus liegt dabei auf der Analyse von Biofilmen, Ansammlungen von Keimen auf Oberflächen, die sich etwa in Harnkathetern ausbreiten. Will man Materialien konzipieren, die das Entstehen von Biofilmen unterbinden, muss jedoch zuerst geklärt werden, wie es überhaupt zum gefährlichen Keimwachstum kommt. Denn gegen Unbekannt lassen sich keine passenden Schutzmassnahmen entwickeln. Und hier tappte die Medizin bisher wortwörtlich im Dunkeln – denn es war weitgehend unbekannt, was eigentlich im Inneren eines Katheters wächst.
Die Empa-Forscherin Qun Ren ist den Geheimnissen im Inneren von Polymerschläuchen auf der Spur. Gemeinsam mit den St. Galler Spitalärzten untersuchte sie die Rückstände aus Harnleiterschienen von knapp 90 Patienten. Die Verwendung eines Stents im Harnleiter ist eine gängige Prozedur, etwa bei der Behandlung von Nierensteinen. «Wird ein derartiger Stent eingesetzt, treten jedoch häufig Beschwerden und Harnwegsinfekte auf», sagt Ren. So auch bei den untersuchten Patienten: Nach einer vergleichsweise kurzen Verweildauer im Körper von rund 3 Wochen hatten sich in den Schläuchen nicht nur Kalziumkristalle aus dem Urin abgelagert, die Forscherin fand in den Proben auch Bakterienansammlungen. «Auf der Materialoberfläche hatten sich Biofilme gebildet, aus denen sich Bakterien anzüchten liessen», so die Forscherin.
Das Wesen im Schlauch
Und genau mit diesen Biofilmen halten die Wissenschaftler das vermutlich erfolgreichste Lebewesen der Welt in Händen: Ansammlungen von Bakterien, eingebettet in eine selbst produzierte schleimige Matrix, die sich wie ein einziger grosser Organismus verhält. Und sie waren schon lange vor uns da. Biofilme finden sich bereits in den ältesten bekannten Fossilien unserer Erdgeschichte. Es wundert nicht, dass sie sich seither hartnäckig gehalten haben und unter widrigen Bedingungen, etwa in Harnkathetern, gedeihen, denn sie verfügen über erstaunliche Überlebensstrategien.
Dank der gelartigen Schicht aus Biopolymeren sind die zusammenlebenden Bakterien geschützt, beweglich und miteinander verbunden. Munter tauschen sie nützliche Erbgutstücke untereinander aus, kommunizieren über chemische Signale und melden an die Oberfläche, wenn die tieferen Schichten der «WG» Hunger leiden. Antibiotika und Desinfektionsmittel durchdringen den Film kaum, und bei Bedarf senden sie einen Trupp von Pionieren an einen neuen Ort und gründen weitere Kolonien, einem metastasierenden Tumor gleich.
Geschickt wie ein Gecko
Was in der Natur erfolgreich ist, kann im Spital für Patienten böse enden. Ziel ist es daher, neue Materialien beispielsweise für Katheter zu entwickeln, um das Risiko von Infektionen zu senken. «Ein Schlüsselereignis bei der Entstehung eines Biofilms ist der Moment, wenn sich frei bewegliche Bakterien auf der Oberfläche anheften», erklärt Ren. Dabei setzen manche der Mikroorganismen auf denselben Trick wie Geckos, die kopfüber an einer Glasscheibe Halt finden: Sie nutzen Van-der-Waals-Kräfte, Wechselwirkungen zwischen ihren eigenen Molekülen und jenen der Oberfläche, die ihnen ein neues Zuhause bieten soll. Andere Exemplare beschichten die Schläuche mit einem passenden Überzug, was das Niederlassen auf der Oberfläche unterstützt. «Um die Bakterien zu bekämpfen, muss man daher bereits den Prozess der Anheftung verhindern», so Ren.Voraussetzung für praxistaugliche Materialien und Beschichtungen, die sich den Keimen widersetzen, ist der lückenlose Forschungs- und Entwicklungstransfer «from bench to bedside». Bewähren kann sich ein Material nur dann, wenn die Analysen im Labor so realitätsnah wie möglich sind. Die Empa-Forscher haben daher ein mehrteiliges Labor-Modell entwickelt, die den Bedingungen im Spital so nah wie möglich kommen. Potenzielle Katheter-Kandidaten werden hierbei im Bioreaktor von Flüssigkeiten durchspült, wie es einer echten Harnleiterschiene im Körperinneren widerfährt. Untersuchungen aller vorhandenen Mikroorganismen mittels Konfokalmikroskopie, Bakterienkultur und Erbgutanalyse folgen. Gleichzeitig werden die mit Kalziumkristallen bewachsenen Materialienoberflächen mittels Röntgenanalyse charakterisiert. «Nur wenn wir die Bakterien in den Biofilmen genau kennen, können wir sichere und hocheffiziente neue Materialien herstellen, die sich ihnen widersetzen», sagt Ren.
Anhand der Proben aus dem Kantonsspital St.Gallen konnte nun als weitere Grundlage des Modells genau gezeigt werden, was im Körper mit Kathetern aus herkömmlichen Materialien passiert. Da es sich um Patienten handelte, die vor dem Einsetzen des Stents keine Anzeichen einer Infektion zeigten und den Schlauch lediglich kurz im Körper trugen, waren die gewachsenen Biofilme erwartungsgemäss mild ausgeprägt. Klar ist aber bereits jetzt, dass manche Erregerarten oft gemeinsam in einer bestimmten Gruppe auftreten. So wiesen manche Patienten vor allem schädliche Enterobakterien in ihren Proben auf, während andere beispielsweise über Erregerarten wie Milchsäurebakterien verfügten, denen man eine möglicherweise schützende Wirkung zuschreibt. Wie diese Erregergruppen der Patienten mit dem Risiko einer Spitalinfektion zusammenhängen, werden die Forscher nun untersuchen. Ebenfalls wird derzeit eine spezielle Ausstattung von Oberflächen für bestimmte Keimträger diskutiert. In einem nächsten Schritt will das Team nun Proben von Langzeitbehandlungen und infizierten Patienten unter die Lupe nehmen.